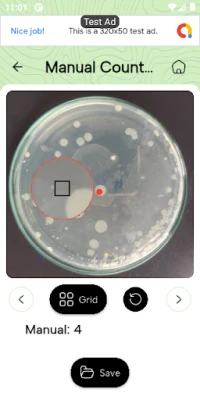
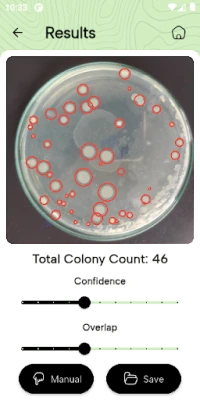

Latest Version
Version
1.4.0
1.4.0
Update
September 11, 2025
September 11, 2025
Developer
Chathura Chamikara
Chathura Chamikara
Categories
Health
Health
Platforms
Android
Android
Downloads
0
0
License
Free
Free
Package Name
com.cchamikara.colony_counter_app
com.cchamikara.colony_counter_app
Report
Report a Problem
Report a Problem
More About Colony Counter: Bacteria
Colony Counter: Count bacteria colonies in a petri dish with a photo! 🧫🧪🦠
Features:
Easy to use: Just take a photo of your petri dish and the app will automatically count the colonies.
Accurate results: The app uses a machine-learning algorithm to ensure accurate counts.
Save and share your results: Save your results for later or share them with your colleagues.
Manual Counter: to count the colonies easily.
Download now and start counting! 🎉🎉🎉
The colony counter app is still in the testing phase and may not be reliable. Some colonies may not be identified due to technical limitations. Any feedback would be appreciated.
#Colony #CFU #Bacteria #Counter #Scope
Easy to use: Just take a photo of your petri dish and the app will automatically count the colonies.
Accurate results: The app uses a machine-learning algorithm to ensure accurate counts.
Save and share your results: Save your results for later or share them with your colleagues.
Manual Counter: to count the colonies easily.
Download now and start counting! 🎉🎉🎉
The colony counter app is still in the testing phase and may not be reliable. Some colonies may not be identified due to technical limitations. Any feedback would be appreciated.
#Colony #CFU #Bacteria #Counter #Scope
Rate the App
Add Comment & Review
User Reviews
Based on 0 reviews
No reviews added yet.
Comments will not be approved to be posted if they are SPAM, abusive, off-topic, use profanity, contain a personal attack, or promote hate of any kind.
More »










Popular Apps

OCEARCH Shark Tracker™Ocearch.org

Wells Fargo Vantage℠Wells Fargo Mobile

Minutes Audio Meeting RecorderAbdullah Riaz

Infinite HittingBranded MINDBODY Apps

Cleerely StatedCleerely Stated, LLC

AI MINUTESalt inc.

NHT OnlineNational Housing Trust

Royal KingdomDream Games, Ltd.

Too Good To Go: End Food WasteToo Good To Go Aps

AjoMoney: Group SavingsRank Capital Limited
More »










Editor's Choice

Nearby SharingShortDevelopment

Samsung Smart Switch MobileSamsung Electronics Co., Ltd.

Google’s Find HubGoogle LLC

foodpanda: food & groceriesFoodpanda GmbH a subsidiary of Delivery Hero SE

ExploreExplore SAS

Explore Abu DhabiRiver Ventures FZC – LLC

Solid Explorer File ManagerNeatBytes

IQAir AirVisual | Air QualityIQAir AG

MOLDINOMOLDINO Tool Engineering, Ltd.

Chester Tech Gear watch faceCHESTER WATCH FACES